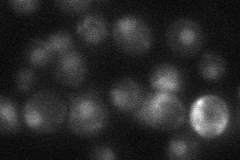
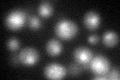

View description
Protein involved in silencing; may recruit or stabilize Sir proteins; role in Rad51-dependent homologous recombination repair and intra S-phase DNA damage checkpoint; member of the RENi (Rad60-Esc2-Nip45) family of SUMO-like domain proteins
Localization:
Intensity:
Fold change:
Significance:
-
C’ GFP library in SD

nucleus20.27 -
N' NOP1pr-GFP in SD

nucleus74.6563 -
N' TEF2pr-mCherry in SD

nucleus96.0814 -
N' NATIVEpr-GFP in SD
nucleus18.4639 -
N' TEF2pr-VC and Cyto-VN in SD

nucleus41.9947 -
C’ GFP library in SD+DTT
nucleus23.821.17No -
C’ GFP library in SD+H2O2

nucleus24.711.21No -
C’ GFP library in Starvation Media

nucleus19.40.95No -
C’ GFP library on the background of Pup2-DaMP

nucleus -
C’ GFP library on the background of CCT mutant

nucleus23.47981.15801No
